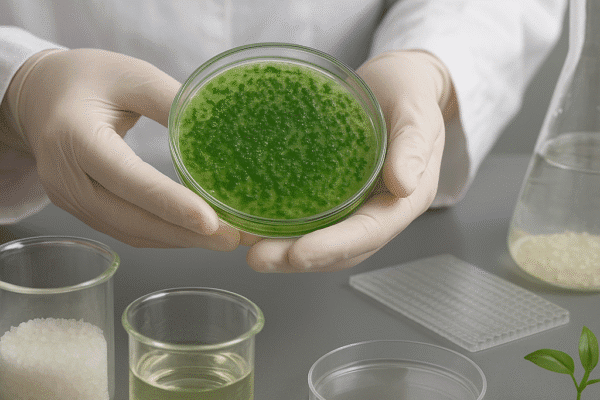

Zastosowanie bakterii w produkcji bioplastików
Bioplastiki stanowią coraz ważniejszy element branży materiałów polimerowych, a ich produkcja z udziałem bakterii odgrywa kluczową rolę w kierunku zrównoważonego rozwoju. Proces syntezy za pomocą mikroorganizmów otwiera szerokie możliwości wykorzystania surowców odnawialnych i ograniczenia negatywnego wpływu na środowisko. W poniższych…